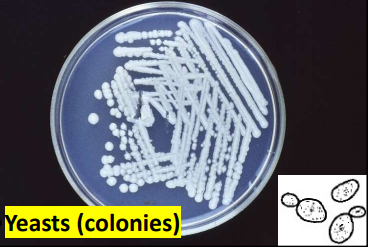

fungi habitat
widely distributed
environment
human
animal
two ways of classifying fungi
phenotypic
phylogenetic
two names under phenotypic classification
anamorph name
teleomorph name
whats the anamorph name
on the basis of morph of asexual form
whats the teleomorph name
the name on the basis of the sxual form
whats a mitosporic fungi
one that has no known sexual form
five phyla of the phylogenetic classification
microspora
ascomycota
basidiomycota
blastocladiomycota
glomeromycota
sexual reproduction
zygospora
ascospora
basidiospora
two main types of spores of asexual spore formation
conidia
sporangiospores
what are conidia
asexual spore formation on conidiophores
what are sporangiospores
asexual spore formation within a sporangium
different styles of asexual spore formation
arthroconidia
blastoconidia
chlamydoconidia
macroconidia
microconidia
phialoconidia
sporangiospores
are fungi uni or multicellular
they can be either
fungi cell wall features
- cell wall
- septa
- cytoplasma membrane
- nuclear membrane
- nucleus
- nucleolus
- ribosomes
- endoplasmic reticulum
- mitochondria
what would you find in the cell wall
chitin, hemicellulose, mucopolysacharide, protein, lipid
where do you usually find septa
in hyphae
three morphological forms of fungi
moulds
yeasts
dimorphic
what are moulds
grow as branching filaments called hyphae
yeasts what are they
oval cells
dimorphic fungi what are they
they occur in both forms, moulds and yeats
dimorphic fungi are which type at environmental temp
mould
dimorphic fungi are which type in the body
yeasts
colony types
moulds - mycelium
yeasts - colony
staining for fungi
simple
Gr+
PAS - in tissue section


